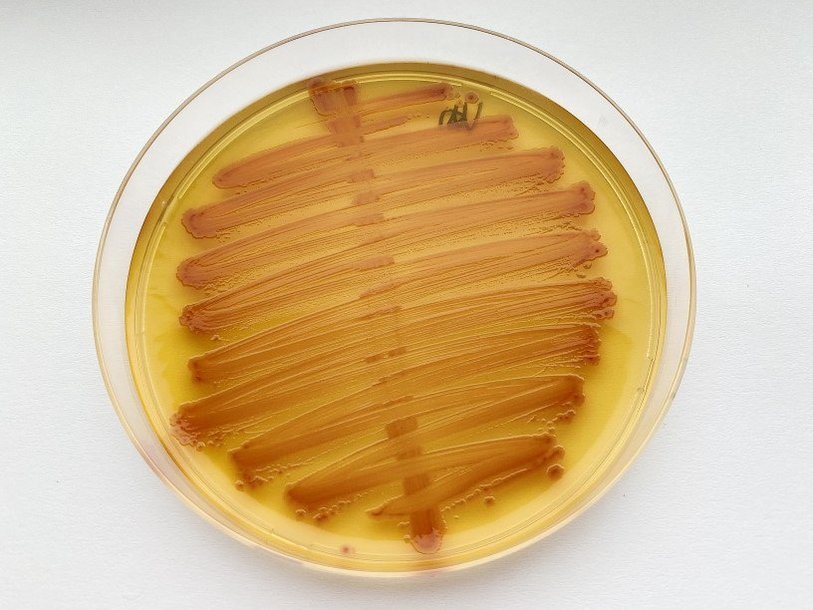

Екатерина Беленко: Промикробы: Впился как клещ
Фото: Екатерина Беленко
Фото: Екатерина Беленко Все знают, что укусы клещей опасны, но дело ведь не в самих клещах, а в тех крошечных существах, которые с этим укусом могут проникнуть в вас. Одними из этих существ являются бактерии рода Borrelia, а вызывают они, соответственно, боррелиоз, другое его название — болезнь Лайма. И кисленькие фрукты тут совсем ни при чем.
⠀
Возможно, это только у меня так, но энцефалит для меня с детства был на слуху, им пугали взрослые. А вот болезнь Лайма менее раскручена. Хотя на самом деле болезнь Лайма является самым распространённым среди заболеваний, передаваемых при укусах клещей. Возбудители болезни Лайма относятся к порядку спирохеты — они длинные, тоненькие и спирально закрученные. Боррелии — не единственные представители этого порядка, которые пакостят людям, там все родственнички как на подбор: Leptospira, вызывающая лептоспироз, Spirillum вызывает лихорадку укуса крыс, Treponema pallidum, более известна как бледная трепонема, — возбудитель сифилиса, Borrelia recurrentis — возбудитель возвратного тифа, и другие.
⠀
Впервые сообщения о системном клещевом боррелиозе появились в 1975 году в США, где в штате Коннектикут, в небольшом городке Олд-Лайм, были зарегистрированы случаи этой болезни. Сначала, конечно, никто не знал, что это за болезнь, людям ставили диагноз «ювенильный ревматоидный артрит», и распространенность этого заболевания в Коннектикуте превышала средние показатели США и других стран в 100 раз. Наконец, команда медиков установила, что болезнь возникает после укуса клещей.
⠀
Ещё через пару лет смогли определить основного переносчика — им оказался иксодовый клещ. А в 1982 году Вилли Бургдорфер впервые выделил из клещей спирохетоподобные микроорганизмы рода Borrelia, впоследствии названные Borrelia burgdorferi. Американские исследователи нашли Borrelia burgdorferi в крови и спинномозговой жидкости больных боррелиозом, а у ряда пациентов даже удалось обнаружить то, о чём сейчас все мечтают, — антитела.
⠀
Инкубационный период болезни Лайма обычно насчитывает 5–11 дней, но иногда характерные симптомы могут возникнуть и через месяц после контакта с клещом. Главный признак инфицирования — появление на месте укуса красного пятна кольцевой структуры с четкими контурами, которое зудит и опухает. Его называют мигрирующей эритемой, потому что оно иногда перемещается.
⠀
Параллельно наблюдаются симптомы чего-то похожего на грипп и не только на него: ломота в суставах, головная боль, повышенная температура, утомляемость. Через 3–8 недель покраснение исчезает, ОРВИ тоже довольно быстро проходит, и человек чувствует себя относительно здоровым. Но болезнь всё это время прогрессирует. У человека появляются проблемы в разных органах. Чаще всего возникают боли в суставах, нарушается работа сердечно-сосудистой и нервной систем, ухудшаются память, зрение и слух, возникают неврологические расстройства, снижается иммунитет, из-за чего могут присоединяться другие инфекции. Нередко врачи не сразу диагностируют болезнь Лайма и назначают лечение конкретного органа, но проблема носит системный характер. И причина ее — маленькая извилистая боррелия.
⠀
В большинстве случаев человек излечивается с помощью антибиотиков. Исход заболевания во многом зависит от своевременности и правильности постановки диагноза и раннего начала лечения инфекции. Несвоевременная и неадекватная терапия может привести к развитию «поздней стадии», которая трудноизлечима и может закончиться инвалидностью или даже смертью заболевшего. На территории США не позднее 72 часов после укуса и удаления клеща рекомендуется профилактический однократный приём доксициклина, который снижает риск заболевания и уменьшает проявление симптомов в случае их возникновения.
Смотрите также: Екатерина Беленко Промикробы: Бич Божий Екатерина Беленко Промикробы: Техногенная катастрофа Екатерина Беленко Промикробы: Гонка вооружений Екатерина Беленко Промикробы: Инфекция наносит ответный удар